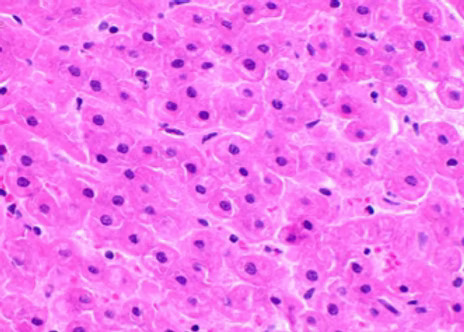
MorCor pathology Hor

Biopsy
"Thinking of MorCor® right now with these horrible stereotactic breast core biopsies that I just received. Tons of contamination with blood, the tissue was all fragmented and going every which way. It literally looks like they ran it over with a truck before giving it to me. This makes it much harder to look at under the microscope. I'm waiting for you to save us!"
Pathology Department Chair
Management of severe diseases starts with excellent biopsy samples.
RESTARI is a full-line biopsy provider with a portfolio that includes innovative, new technologies that deliver superior tissue samples and value based, high quality, complementary biopsy devices and accessories.
60,000 kidney biopsies are performed in the U.S. every year.
1,000,000 prostate biopsies are performed in the U.S. every year.
1,300,000 breast biopsies are performed in the U.S. every year.
RESTARI's Biopsy Portfolio:
MorCor® (coming soon) uses patented technology to capture biopsy samples of superior quality and size so skilled physicians have more of the best material to work with.

RESTARI's MorCor® full core biopsy device takes excellent biopsy specimens without the fragmentation of side notch devices.

"Linear samples exhibited no crush artifact or cellular distortion".
(RESTARI Data on File)
"Overall the specimens were 90% better than similarly acquired tissues." A prominent pathologist's summary.
(RESTARI Data on File)
MorCor theoretical sample volumes surpass side notch volume.

(RESTARI Data on File)

MorCor®'s samples weighted notably more than prominent competitor's samples.
(RESTARI Data on File)


